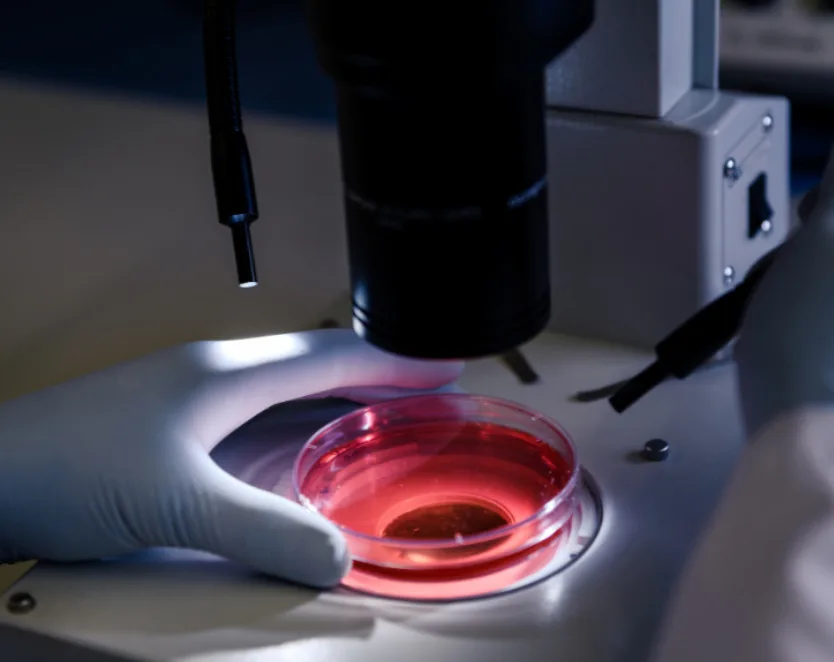

DSS: Redefining Biotechnology & Life Science in India
- About Us
- Products & Services
PRODUCTS & SERVICES
- Applications & Specialities
All Applications & Specialities
- Brands
- Contact Us
-

-
 0
0
- ☰
- About Us
- Products & Services
- Applications & Specialities
- Brands
- Brand - Life Sciences
- 3i
- ABBERIOR INSTRUMENTS
- Abbott Molecular
- ADS Biotec
- APPLIED SPECTRAL IMAGING
- BioAir Tecnilabo
- DAKO (AGILENT)
- Eden Tech
- Elveflow
- ENTROGEN
- EUROCLONE
- EVIDENT
- Genea
- Hamamatsu Photonics
- Invivoscribe
- MASTER DIAGNOSTICA
- MBF BIOSCIENCE
- Medical Tek Co. Ltd
- MILESTONE MED SRL
- Molecular Machines & Industries
- MRC HOLLAND
- Onward Assist
- Profound
- SCIENTIFICA
- SpaceGen
- Seqlo
- µCyte
- Brand - Industrial
- Brand - Life Sciences
- News & Events
- Career
- Contact Us
- Testimonial
- Blogs
- R&D
- CSR
- Press Release
Pioneering Innovation in Molecular Diagnostics & Biotechnology
Advancing healthcare with cutting-edge technology and precision, empowering a healthier future through molecular innovation.
Our Products & Services


Redefining Biotechnology & Life Science in India
DSS Imagetech excels in operational excellence, product leadership, & customer satisfaction, focusing on innovative medical technologies & collaborations. Committed to molecular research and diagnostics, they develop Real-Time PCR kits for food testing and cervical cancer screening, advancing India’s healthcare sector.

DSS Imagetech is a New Delhi-based company with offices all over India providing cutting-edge solutions to researchers & clinicians in various fields of Life Sciences & Healthcare. Driven by the mantra “Inspired By Technology”, DSS Imagetech is recognized for its expertise in Micro-Imaging, Clinical Diagnostics, Medical Equipment and R&D.
About DSS ImagetechArea of Expertise
DSS Imagetech is a leading provider in the fields of Molecular Diagnostics, Life Sciences, and Biotechnology. The company specializes in offering cutting-edge solutions for microscopy, micromanipulation, and imaging technologies. It partners with global innovators to bring advanced medical and research equipment to the Indian market. DSS Imagetech is also prominent in the IVF segment, providing comprehensive solutions that include advanced imaging systems and genetic testing kits.
BRANDS
3i
3i was established in 1995 by a group of young and dynamic scientists working in the fields of cell biology, immunology, neuroscience, and computer science. At 3i, they aim to provide advanced multidimensional microscopy platforms, with its modular design and user-friendly technology, that meet the evolving needs of the biological research community.
3i (Intelligent Imaging Innovations) designers and manufacturers provide cutting-edge live cell and intravital microscopy imaging platforms that are driven by 64-bit SlideBook software. DSS is a key distribution partner for their representation in India.
ABBERIOR INSTRUMENTS
Abberior Instruments GmbH, a spin-off from the Max Planck Institute of Biophysical Chemistry, Göttingen and the German Cancer Research Institute, Heidelberg, was founded by Dr. Gerald Donnert, Dr. Alexander Egner, Dr. Benjamin Harke, Prof. Dr. Dr. h.c. Stefan W. Hell (who was awarded the Nobel Prize in 2014), Dr. Lars Kastrup, Dr. Matthias Reuss and Dr. Andreas Schönle in 2012.
The company is based in the Laser Laboratorium Göttingen GmbH technology park which is located in the north campus of the University of Göttingen, Germany. DSS is proud to be the distributor for Abberior in India.
Abbott Molecular
Abbott Molecular Diagnostics, a world leader in the field of DNA based molecular diagnostics, has its solutions for real-time PCR (Infectious Diseases) and FISH (Vysis) used to conduct sophisticated analysis of patient DNA and RNA. Using Abbott Molecular Diagnostics products, physicians can access critical information by early detection of pathogens and subtle changes in patients’ genes, with the following benefits:
Early Diagnosis
Selection Appropriate Therapies
Monitoring Disease Progression
ADS Biotec
ADS Biotec and its parent ADSTEC (Japan) are global leaders in the development, manufacture, and sale of automated instruments and consumables for use in cytogenetic, pathology and research laboratories. The technology and services empower customers to maintain a high degree of quality and consistency while increasing productivity.
Acquisition of Genetics Assays and Platforms (GAP) Division, Transgenomic, has given ADS Biotec a truly global existence in development, sales, and support operations in three continents and with users in over 30 countries. Genial Laboratory Automation was also acquired by ADS Biotec in order to further strengthen its global leadership and broadened its portfolio of automated instruments and consumables in the cytogenetics, pathology and research laboratories.
APPLIED SPECTRAL IMAGING
Applied Spectral Imaging develops computer-aided systems for use in diagnostics by pathology, cytogenetic and research laboratories and helps provide labs with accurate, repeatable and standardized analysis of karyotyping, FISH, CISH, quantitative IHC, as well as SKY (spectral karyotyping) spectral imaging for research applications. Their further presence in India is led by DSS Imagetech.
Arck Technologies
Established in September 2015, ARCK Technologies has strong foundation with professionals who have extensive experience in the medical industry. With the expertise gained from working with well-known companies such as Beckman Coulter, Roche, Transasia Bio Medicals, and Medtronic, Arck Technologies is well-positioned to offer high-quality products and services to its customers. Their USP is “Manufacturing IVF consumables with MEA / LAL / SMMA Quality Control tested, at an affordable price” ARCK Technologies manufactures IVF consumables at affordable prices, optimize their production processes, source raw materials efficiently, streamline quality control processes, and have partnered with several companies to offer a complete basket of products.
BioAir Tecnilabo
BioAir, an Italian leader in contamination control equipment, caters to the needs of biomedical research and biopharmaceutical production. In 2021, BioAir joined the Tecniplast group, a global frontrunner in laboratory animal science equipment. BioAir provides a comprehensive suite of laboratory solutions, combining BioAir’s expertise in contamination control with Labosystem’s laboratory furnishings and KW’s temperature-controlled equipment. This unified approach offers clients an extensive and seamless laboratory experience. DSS Imagetech is committed to advancing laboratory technology and providing high-quality solutions for scientific research. BioAir, part of the renowned Tecniplast family, enables us to offer a robust selection of contamination control equipment ideal for cutting-edge biomedical research. DSS Imagetech and BioAir aim to redefine laboratory standards, enhancing research efficiency and safety across diverse scientific fields and biopharmaceutical production.
DAKO (AGILENT)
Agilent, a leader in life sciences, diagnostics and applied chemical markets, provides laboratories across the globe with instruments, services, consumables, applications and expertise that enable customers to gain the insights they seek. Agilents Diagnostics and Genomics Group markets Dako products to be a world leader in anatomic pathology & tissue-based cancer diagnostics. DSS has been representing this product line since 2007.
After acquisition of Dako by Agilent in 2012, the solutions provided have focused on Anatomic Pathology, Kits, Antibodies, Reagents, Specific Proteins, and Other Products, PharmacoDiagnostic®, Primary Antibodies, Visualization Systems, Multipurpose Antibodies, Secondary Antibodies, Control Reagents, Ancillaries, Clinical Immunochemistry, Flow Cytometry, and MHC Dextramers.
Eden Tech
Eden Tech facilitates advancements in microfluidic technology by offering a comprehensive suite of tools, processes, and services that notably reduce the duration of the prototype-to-product cycle. Through our subsidiary, Eden Materials Solutions, we furnish efficient prototyping tools, expediting the development process. All our systems are meticulously designed to seamlessly facilitate a swift transition to industrial-scale production. Harness the potential of Eden Materials to expedite your innovation pipeline in the realm of microfluidics. Furthermore, Eden Tech underscores the significance of microfluidics within the industry by providing solutions tailored for high-volume processing. Emulating Nature’s remarkably efficient and compact systems, Eden Tech has meticulously engineered products aimed at water purification and sustainable energy generation, aligning with our commitment to environmental sustainability.
Elveflow
The Elveflow develops a range of state-of-the-art microfluidic instruments, for all kinds of microfluidic operations. Their microfluidic systems can be used in numerous different fields, similar as biology, chemistry, medicine delivery, but also for cosmetics and food. The Microfluidics moment has an outstanding impact on healthy mortal lifetime, drug, depollution technologies. Moment, They are here to boost every kind of microfluidic exploration and operation with their instruments and moxie. They have a decade of experience, they can take you through OEM results and easy integration for your microfluidic dilemmas, be it fluid running, pressure control and flow dimension, fine-tuning of gas and liquid. Now DSS is with Elveflow and their results are a grounded range of microfluidic instruments, favoured by scientists for over a decade.
Compatibility of ElveFlow Key Products – ElveFlow Key Products
ENTROGEN
EntroGen is a US-Based biotechnology company with its primary focus on molecular diagnostics in the fields of hematology and oncology. It’s growing commercial portfolio of multiple products, including real-time PCR and NGS based tests, is used to guide and monitor targeted therapies for various malignancies. EntroGen delivers reliable and innovative tools to researchers and clinicians in every corner of the globe.
EntroGen’s products (RUO) endorsed by DSS are as follows:
Mutation Analysis Kits
Genotyping Kits
Quality Assessment Kits
EUROCLONE
EuroClone SPA is an Italian company represented by DSS since 2016, for its cytogenetic products, mainly culture media and FISH equipment. With a varied array of products, Euroclone has vast experience in the field of cytogenetic analysis, helping them to develop a perfect combination of media, plastic supports, synchronizing agents and types of equipment for pre and postnatal analysis.
Automation and standardization of procedures in the Cytogenetics Labs are answerable by EuroClone through its complete range of instruments that enables the user to improve manual operations required on chromosome preparation steps. Our devices ensure excellent results that can be reproduced in any environmental condition and also lessen the time and workload.
EVIDENT
Evident is a global leader in advanced imaging and microscopy technology, with a rich history of innovation. They design and manufacture state-of the-art instruments and solutions that are trusted by professionals across healthcare, research, and education sectors. Specializing in high-quality imaging systems, Evident’s products deliver unparalleled precision and reliability for a wide range of applications, from medical diagnostics to scientific research, supporting critical work in laboratories, medical institutions, and universities worldwide.
DSS Imagetech is the partner in India, bringing their cutting-edge solutions in microscopy, imaging, and diagnostic technology to the Indian market. By partnering with Evident, we are committed to providing our customers with exceptional tools that meet the highest standards of quality, innovation, and reliability. From advanced microscopes to versatile imaging systems, we\ aim to support professionals across healthcare, research, and clinical practice with reliable, high-performance products designed to enhance precision and facilitate scientific discovery.
Genea
Genea Biomedex is a pioneering leader in biomedical technology, dedicated to advancing healthcare through innovative solutions. The state-of-the-art products and services are designed to improve patient outcomes and streamline clinical workflows. With a commitment to excellence and a focus on cutting-edge research, Genea Biomedex bridges the gap between scientific discovery and practical application. Genea collaborate with healthcare professionals worldwide to deliver reliable, high-quality medical devices and technologies that enhance diagnostics, treatment, and patient care. At Genea Biomedex, innovation meets precision to shape the future of healthcare.
Hamamatsu Photonics
Hamamatsu Photonics products and technology include optical sensors, light sources, and systems that use these components. They are applied to various new technologies and devices to support people’s lives and help realize a more comfortable and prosperous society. Hamamatsu products are widely used for state-of-the-art medical equipment, test and inspection systems, microscopes that reveal the functions of cells, and giant telescopes that explore the mysteries of the universe.
Invivoscribe
Invivoscribe, Inc., (IVS) a globally focused biotechnology company has over 25 years of expertise in precision diagnostics and clinical trial service thereby creating groundbreaking excellence in the field of healthcare. In India, DSS Imagetech is helping IVS for their clonality based testing, NGS-MRD based tests and their services (via Lab Services PPM) for hematology. Their Clonality tests are based on Gel as well as ABI fluorescence while NGS tests are based on Illumina’s MiSeq and Thermo Fisher’s Ion Torrent S5/PGM.
MASTER DIAGNOSTICA
Master Diagnostica, a biotechnology company, incorporated in 1996 and a part of the “Vitro Group” Granada, Spain, is devoted to R&D in Pathology via the discovery of new diagnostic procedures and implementation of current protocols using highly innovative technologies for in vitro diagnosis of cellular and molecular pathology in the fields of oncology and infectious diseases. They are distributed in India by DSS
MBF BIOSCIENCE
MBF Bioscience designs quantitative imaging software for stereology, neuron reconstruction, and image analysis that are integrated with the world’s leading microscope systems, to enable your research.
Our development team and staff scientists work actively with leading bioscience researchers who continually strive to refine the products that are in tune with the latest scientific advancements in the field.
MBF Bioscience products include the latest protocols available in the areas of design-based stereology, neuron reconstruction, brain mapping, virtual slides, autoradiography or worm tracking, to give our customer’s cutting-edge results that are accurate.
Medical Tek Co. Ltd
Medical Tek Co. Ltd (MDTK) is based in Taiwan and has proprietorship in real time accurate conversion of endoscopic imaging from 2D to 3D. MDTK develops and manufactures imaging systems that find application in minimally invasive surgery (MIS). MDTK, located in Taichung Central Taiwan Science Park, connects with high-tech companies in central Taiwan and also has a good relationship with IRCAD/AITS in Changhua Taiwan, which is the biggest MIS training center in Asia.
MonoStereo Visualization system is designed to have stereo visualization from monoscopic images during minimally invasive surgeries. To do this, the device, MonoStereo, needs to connect to a 2D endoscopic system and a 3D monitor display. During the procedures, operators can wear the 3D glasses to get depth feedback in real-time.
In 2018 DSS Imagetech tied up with Medical Tek to bring this technology to the Indian market to meet the needs of surgeons by presenting them with clearer and accurate images during surgeries.
MILESTONE MED SRL
Milestone is an Italy-based company founded in 1988, specializing in advanced microwave instrumentation for analytical and organic chemistry laboratories. It was the first company to design and build microwave tissue processor for histology labs and subsequently created the first, fully automated, high-throughput microwave processor.
From the surgery suite to the laboratory, Milestone provides for preservation of vacuum-sealed “fresh” specimens through the system for vacuum transfer of biospecimens, which uniformly monitors both specimen temperature and time.
Milestone’s products include a wide range of workstations and macro digital imaging systems for both grossing and autopsy rooms with a focus on pre-analytical aspects. The product range also includes instruments that improve cryoembedding and staining processes leading to high-quality frozen sections in less than 10 minutes.
Milestone’s Medical equipment range is represented in India by DSS from 2017 onwards providing solutions for enhancement of quality in Immunohistochemistry and offer same day solution for early disease management and shorter TAT.
Molecular Machines & Industries
Molecular Machines & Industries (MMI) is a Germany based company that deals in single-cell handling, laser microdissection, whole slide imaging and optical tweezer for a wide range of clinical and research-based applications. It is the best leading industry in the field of microscope-based micromanipulation solutions for the material sciences, life sciences, and healthcare sectors. It has a unique competence in microdissection, micromanipulation and imaging.
MRC HOLLAND
MRC Holland is a company based out of The Netherlands which has a proprietary technology – MLPA® (Multiplex Ligation-dependant Probe Amplification (MLPA®), a multiplex PCR method which enables detection of variation in copy number (CNV) of up to 60 DNA sequences in one reaction and can handle up to 96 DNA samples at a stretch with results being available within 24 hours.
Introduced in 2002, MLPA® is a gold standard in CNV detection and has proven to be a robust and easy-to-use techniques, and since it is highly sensitive to even a single nucleotide difference, it has applications in detection of point mutations.
MLPA®, when used in combination with a methylation-sensitive restriction enzyme, can be applied to detect DNA methylation patterns (MS_MLPA®). The first Melt Assay for spinal muscular atrophy (SMA) newborn screening was launched in 2018 and the first digitalMLPA® technique based assay was launched in 2020. digitalMLPA® combines the trusted quality of MLPA® with the power of next-generation sequencing to examine many more target sequences in a single reaction.
In diagnostics and research of both human genetic disorders and tumors, MLPA® is used in laboratories worldwide.
Onward Assist
Onward Assist leverages the advancements in computational pathology and digital pathology to provide a suite of user-friendly and robust technological tools. These tools support users across various domains, including academics, lab management, and expeditious reporting of pathology slides. DSS along with Onward Assist is dedicated to improving cancer diagnosis and streamlining the pathology reporting workflow in the country. The goal is to make these processes more accessible, precise, and efficient, with a substantial reduction in reporting time by 30-40%.
Profound
TULSA-PRO® is a medical technology designed to provide radiation-free ablation of the prostate while protecting the surrounding structures like the urethra and rectum. It offers a customizable and predictable approach to prostate ablation, allowing surgeons to define the specific volume to be treated. TULSA-PRO® has shown potential in various applications, including intermediate stage prostate cancer, localized radio-recurrent cancer (cancer that has returned after previous treatment with radiation), retention and hematuria palliation in locally advanced prostate cancer (managing urine retention and blood in urine in advanced cases), and treating the transition zone in large volume benign prostatic hyperplasia (BPH) cases. The technology has received the CE mark, indicating compliance with European health, safety, and environmental protection standards, and it has also obtained 510(k) clearance from the U.S. Food and Drug Administration (FDA) in August 2019. This clearance allows TULSA-PRO® to be marketed and used in the United States.
SCIENTIFICA
Scientific specializes in types of equipment for electrophysiology, multiphoton imaging, and optogenetics studies. They manufacture high-quality instruments for universities, pharmaceutical companies, and research labs in more than 40 countries located across the globe, with the significant business being led by DSS Imagetech in India. With this we help researchers gain a clearer understanding of the nervous system and neurological diseases like Alzheimer’s, Parkinson’s and Epilepsy.
Sol Inc
Sol Inc. is a disruptive bio-tech company with semiconductor lens-free sensors, it indicates that they are using innovative technology in the field of biotechnology. The company name, SOL, also carries the meaning of “”cell.”” This advanced device utilizes LCD lens-free optics and CMOS sensing technology to provide rapid and accurate measurements of various cell parameters. By utilizing semiconductor lens-free sensors, aims to revolutionize the way biological samples are analyzed and measured. Lens-free sensors eliminate the need for traditional optical lenses, offering several advantages such as cost-effectiveness, compactness, and higher throughput. With this technology, Sol Inc. may be able to provide advanced solutions for various applications in the field of biotechnology. Lens-free sensors can be used for imaging and analyzing cells, microorganisms, and other biological samples without the limitations of conventional lenses. This approach may enable faster and more efficient analysis, contributing to advancements in fields like medical diagnostics, drug discovery, and research. As a disruptive company, Sol likely aims to challenge existing norms and introduce innovative solutions that can significantly impact the biotech industry. Their focus on semiconductor lens-free sensors suggests a unique approach that combines semiconductor technology with biotechnology, potentially leading to groundbreaking developments in the field.
SpaceGen
Spacegen is a global leader in molecular diagnostics for oncology, dedicated to advancing precision medicine. Backed by ISO 13485 certification, CAP-accredited labs, and strong R&D capabilities, Spacegen provides reliable, internationally recognized solutions for cancer detection and monitoring.
With expertise across NGS, qPCR, Digital PCR, and Nucleic Acid Mass Spectrometry, Spacegen offers over 50+ diagnostic products covering multiple cancer types. Its proprietary RingCap® technology streamlines sequencing, making testing faster, more accurate, and cost-efficient. Guided by the mission of improving public health, Spacegen continues to drive innovation in targeted cancer diagnostic.
µCyte
µCyte (Microcyte)” is a purposefully designed brand that aims to support and enable researchers and clinicians in their endeavour to comprehend the intricacies of life at the microscopic scale. This comprehensive brand encompasses a range of specialized offerings, including the Basic Intracellular Staining Pack, a foundational toolset for effective intracellular staining; the Starter Pack for Confocal Microscopy Reagents, facilitating the initiation of confocal microscopy studies; and Mounting Media/Antifading Reagents, crucial components for preserving and enhancing microscopic specimen visibility. Through its suite of advanced products, µCyte (Microcyte) endeavours to facilitate breakthroughs in microscopic research and enhance the capabilities of professionals in the field of life sciences.
OUR FLAGSHIP PRODUCTS
SLICE – Light Sheet Microscope
SLICE – The New Standard for Accessible Light Sheet Imaging
SLICE™: a paradigm shift in light-sheet microscopy that combines high performance with unprecedented affordability and a compact device footprint. Invented by leading researchers at Columbia University, SLICE delivers advanced 3D imaging capabilities to research labs of all sizes. This innovative system offers high-resolution imaging of biological samples, making it ideal for both individual laboratories and core facilities.
SLICE comes equipped with powerful BrightSLICE software for tera-voxel visualization, seamless image stitching, and sophisticated post-processing. Moreover, it seamlessly integrates with MBF Bioscience’s renowned suite of analytical tools, including Neurolucida 360, NeuroInfo, and NeuroDeblur, providing a comprehensive solution for cutting-edge research in neuroscience and beyond.
Move beyond expensive legacy light sheet microscopes.
- Add to WishlistAdd to Wishlist
NXtec D024 KaryoProfiler
The NXtec D024-A1 KaryoProfiler is a digitalMLPA assay for
genome-wide detection of gross copy number (CN) changes across
all chromosomes, typically at ~2–4 Mb resolution. The assay
combines SALSA MLPA with next-generation sequencing to enable
accurate detection of large chromosomal gains, losses, and
subchromosomal alterations.
The probemix contains over 160 control probes and fragments for
sample identification, cross-contamination detection, and assay
quality monitoring, including assessment of DNA integrity, ligase
and polymerase activity, and hybridisation performance.
Applications
- Characterization of DNA samples with gross chromosomal
abnormalities, including whole-chromosome gains or losses and
subchromosomal CN changes
- Follow-up of abnormal findings from FISH, array CGH, or NGS,
complementing unclear or failed karyotypes
- Monitoring genomic drift in long-term or high-passage cell cultures,
including embryonic stem cells (ESCs) and induced pluripotent stem cells
(iPSCs); frequently affected chromosomes include 12, 17, 20, and X
- Screening and selection of clones prior to functional studies
- Detection of low-level mosaicism or subclones present in ≥30%
of the DNA sample
- Identification of cross-contamination, detecting contaminating
cell fractions as low as 7.5%
Data analysis
Data analysis should be performed using Coffalyser digitalMLPA
software with the appropriate lot-specific product sheet; the software is available free of charge from the MRC Holland website.
- Add to WishlistAdd to Wishlist
FLUOVIEW™ FV5000
The FLUOVIEW™ FV5000 from Evident elevates scientific imaging with unmatched clarity, speed, and quantitative accuracy. Built on a century of optical excellence and advanced further by Evident innovation, the FV5000 delivers superior performance from surface-level structures to deep-tissue imaging in thick, living samples.
Engineered for researchers who demand precision, flexibility, and reproducibility, this next-generation platform simplifies advanced microscopy—helping you focus on discovery, not system limitations.
- Add to WishlistAdd to Wishlist
Tumor Comprehensive Genomic Profiling Panel Assay
The Tumor Comprehensive Genomic Profiling (CGP) Panel Assay is a high-throughput sequencing (NGS)-based solution for the comprehensive analysis of tumor-related genes. Designed for research use only (RUO), it enables precise detection of single nucleotide variations (SNVs), small insertions/deletions (Indels), copy number variations (CNVs), and gene fusions across a 1200-gene panel.
Available Test Format:
24 samples/Kit
- Add to WishlistAdd to Wishlist
Hereditary Cancers Panel Assay
The Hereditary Cancers Panel Assay is designed for comprehensive genetic analysis of hereditary tumor-related genes using next-generation sequencing (NGS). This assay enables accurate detection of single nucleotide variations (SNVs) and short insertions/deletions (Indels) across 58 clinically relevant genes associated with hereditary cancer syndromes.
Available Test Format:
24 samples/Kit
- Add to WishlistAdd to Wishlist
Human Glioma 26 Gene Mutations Detection Kit (High-Throughput Sequencing)
The Human Glioma 26 Gene Mutations Detection Kit is a high-throughput sequencing (NGS)-based assay for the qualitative detection of key glioma-associated genetic alterations. Designed for research use only, the kit analyzes nucleic acids extracted from FFPE or fresh tissue samples, enabling detection of SNVs, indels, gene fusions, CNVs, and chromosome variations (1p/19q co-deletion, chr7 amplification, chr10 deletion).
Sequencing instruments:
Illumina sequencing instruments (Miseq, NextSeq 500/550, Miniseq, etc);
MGI sequencing instruments (MGISEQ-2000, DNBSEQ-G99RS, etc)
Available Test Format:
- Pre-load 16 Tests/Kit
- Pre-load 32 Tests/Kit
- Add to WishlistAdd to Wishlist
Solid Tumors 107 Gene Mutations Detection Kit (High-Throughput Sequencing)
The Solid Tumors 107 Gene Mutations Detection Kit is designed for qualitative detection of 107 tumor-related gene mutations using high-throughput sequencing (NGS). Compatible with both Illumina and MGI sequencing platforms, this kit supports detection of SNVs, indels, gene fusions, CNVs, and MSI from FFPE or fresh tissue samples.
Sequencing instruments:
Illumina sequencing instruments (Miseq, NextSeq 500/550, Miniseq, etc);
MGI sequencing instruments (MGISEQ-2000, DNBSEQ-G99RS, etc)
Available Test Format:
- Pre-load 16 Tests/Kit
- Pre-load 32 Tests/Kit
- Add to WishlistAdd to Wishlist
Thyroid Cancer Gene Mutation Detection Kit (High-Throughput Sequencing)
The Thyroid Cancer Gene Mutation Detection Kit is a high-throughput sequencing (NGS) solution designed for the comprehensive detection of key pathogenic mutations associated with thyroid cancer. Using DNA and RNA extracted from fine needle aspiration (FNA) samples or thyroid tissue, the kit covers 16 DNA-level genes and 87 RNA-level genes (209 fusion forms). It detects single nucleotide variations (SNVs), small insertions/deletions (Indels), and gene fusions, providing a broad molecular profile for research and clinical reference.
Sequencing instruments:
Gene Sequencer Ion PGM; Ion Proton; Ion S5 etc; Illumina sequencing instruments (Miseq, NextSeq 500/550, Miniseq, etc);
MGI sequencing instruments (MGISEQ-2000, DNBSEQ-G99RS, etc)
Available Test Format:
- Pre-load 16 Tests/Kit
- Pre-load 32 Tests/Kit
- Add to WishlistAdd to Wishlist
BRCA1/2 Gene Mutations Detection Kit (High-Throughput Sequencing)
The BRCA1/2 Gene Mutations Detection Kit is designed for the qualitative detection of BRCA1 (NM_007294) and BRCA2 (NM_000059) gene mutations in samples extracted from formalin-fixed paraffin-embedded (FFPE) tissue or peripheral blood of cancer patients. These genes are key biomarkers in hereditary breast and ovarian cancers, consisting of 23 and 27 exons respectively. The assay also detects single nucleotide variants (SNVs) and insertions/deletions (Indels).
Sequencing instruments:
Gene Sequencer Ion PGM; Ion Proton; Ion S5 etc; Illumina sequencing instruments (Miseq, NextSeq 500/550, Miniseq, etc);
MGI sequencing instruments (MGISEQ-2000, DNBSEQ-G99RS, etc)
Available Test Format:
- Pre-load 16 Tests/Kit
- Pre-load 32 Tests/Kit
- Add to WishlistAdd to Wishlist
Oncology Multi-Gene Mutations Detection Kit (High-Throughput Sequencing)
"Oncology Multi-Gene Mutations Detection Kit (High-Throughput Sequencing) is designed for the detection of 482 somatic mutations across 13 key cancer-related genes in patients with non-small cell lung cancer and colorectal cancer. Using advanced Next Generation Sequencing (NGS) technology and RingCap®-mediated amplification, it enables precise identification of single-base mutations, insertions, deletions, and gene fusions. The kit supports personalized therapy decisions by linking gene alterations with clinically recognized targeted treatments.
Sequencing instruments:
Gene Sequencer Ion PGM; Ion Proton; DA8600; Illumina sequencing instruments (Miseq, NextSeq 500/550, Miniseq, etc);
MGI sequencing instruments (MGISEQ-2000, DNBSEQ-G99RS, etc)
Available Test Format:
- Pre-load 16 Tests/Kit
- Pre-load 32 Tests/Kit"
- Add to WishlistAdd to Wishlist
Testimonials & Reviews

Dr. (Prof.), Nitesh Mohan
Professor & Head, Department of Pathology, RMCH Bareilly
DSS's expertise, dedication, and professionalism were outstanding in making the Karyotyping & FISH workshop a great success. Their knowledge and valuable insights empowered all the participants with practical skills, receiving highly positive feedback from both students as well as faculty members.

Dr. Chhaya Chande, Professor & HOD, Microbiology
GGMCJJ Hospitals, Mumbai
“Ms. Megha Dhumal (Assistant Manager- Application) has done a satisfactory demonstration of the running of the Abbott Sample preparation machine model m2000sp and the Abbott RT-PCR machine model m2000rt. We appreciate the effort made by the DSS team under these difficult conditions to help our lab to carry out the imperative Covid-19 tests.”

Dr Sunil K Arora, Professor, Deptt of Immunopathology
PGIMER, Chandigarh
“We are using Confocal Microscope and one Fluorescence Microscope. Both are working fine. The after sales services by DSS have been excellent for functioning & upkeep of the microscopes. The applications support by experts from DSS is very useful. Keep it up!”

Dr Pramod Kumar Bajaj
MD, Spermprocessor Pvt Ltd
“Really excited to see the DSS Pathology solutions exhibition booth at APCON 2019 along with Magnus. We think all the upcoming technology had been displayed along with your efforts to make it Indigenous (Made in India) is highly appreciated. Wish you all the best. Keep it up!”

Dr. Sreejesh S, Associate Professor, Dept of Hematology
PGIMER, Chandigarh
“My experience with DSS so far has been very good till now. We are getting good support in both purchase as well as in troubleshooting. Very good experience with Mr Arun, Mr Manoj, Mr Mahesh and all others from the DSS team.”
Dr Sudha S Murthy, Department of Pathology and Laboratory Medicine
BIACH & RI, Hyderabad
“I am happy with DSS and associated with 19 years and use Dako antibody. Happy with Supply but need improvement.”

Dr S Radhika MD, PhD
Professor, Deptt. Of Cytology & Gynaec Pathology, PGIMER, Chandigarh
“PGI Cytology Dept. has had a long association with DSS- Olympus Microscopy Division. They have provided excellent services- after sales service. The product is also of very good quality. We have had no problems with their products and services are of very good quality.”

Dr Nuzhat Husain
RMLIMS, Lucknow
“Have been using Dako Reagents and Dako antibodies for a while. Services and products have been good and timely.”

Dr Minu Singh
Assistant Professor, PGIMER, Chandigarh
“MRC Holland MLPA products provided by DSS are of good quality, have never faced any quality issues with their product or shipping condition. They provide prompt response upon any query.”

Mr. Krishnani Professor, SGPGI, Lucknow
“My experience with DSS so far has been excellent for the last 30 years- sales and service experience. Microscope products are very useful and sturdy with high precision.”
News & Events
Glow with the FISH Flow
Intensive 3-day hands-on workshop on Fluorescence in situ Hybridization (FISH) This is an exciting opportunity with limited seats to learn from cytogenetics experts with over 10 years of extensive experience...
Webinar – Abberior Super Resolution Nanoscopy: Technologies from its Inventors, Applications & Beyond -Part II: MINFLUX
Webinar Announcement | Microscopy Webinar Series Stay tuned - we’re excited to bring you our second and third webinars from our ongoing microscopy webinar series! abberior, founded as a spin-off...
Webinar – Abberior Super Resolution Nanoscopy: Technologies from its Inventors, Applications & Beyond – Part I: MIRAVA Polyscope
Webinar Announcement | Microscopy Webinar Series Stay tuned - we’re excited to bring you our second and third webinars from our ongoing microscopy webinar series! abberior, founded as a spin-off...
Insights
LUNG CANCER CARE: THE POWER OF PRECISION DIAGNOSTICS & GENOMICS
Lung cancer today is among the most common & serious types of cancer in the world. It happens when abnormal cells in the lungs begin to grow in a way...
How Digital Karyotyping Software Supports Prenatal Genetic Testing
It is a Tuesday morning. A couple is sitting in an OB-GYN office, holding hands so tightly their knuckles are white. They aren't looking at their phones. They are staring...
National DNA Day 2026: Why DNA Matters for Modern Healthcare
Every cell in our body carries DNA, the code of life. April 25 marks DNA Day, it highlights advances in genomic research and encourages education in genetics. While DNA was...
FAQs
DSS Imagetech Pvt. Ltd. provides Lifescience solution products, diagnostic kits, laboratory instruments, reagents, and research consumables used in molecular diagnostics, cytogenetics, and biomedical research.
DSS Image offers a wide range of biotechnology solutions including diagnostic kits, laboratory reagents, research instruments, and consumables used in clinical diagnostics and life science laboratories.
DSS Image products are primarily used by diagnostic laboratories, hospitals, IVF clinics, biotechnology companies, research institutes, and academic institutions involved in life sciences and medical research.
The company supports multiple sectors including healthcare, molecular diagnostics, biotechnology research, genetics laboratories, IVF and pharmaceutical research.
Biotechnology products help scientists study genes, detect diseases, and develop new diagnostic technologies and treatments that improve healthcare outcomes.
Yes, DSS Image offers products and technologies that support genetic testing, cytogenetics research, and molecular diagnostic applications used in modern laboratories.